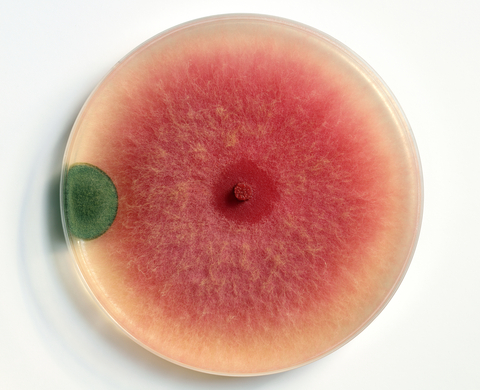
red mold

Before You Go
Get Your FREE Home Cleaning Guide
Simple action items on how to make your home safer- today!

Mold comes in many shapes, sizes, and colors. Most people recognize mold as black, white, or green, but red mold is another type of growth you may see in your home. The important thing to know is that “red mold” is not a single species. Instead, several molds can appear red during certain stages of their lifecycle.
There’s also what many people call “pink mold, ”which is a growth that ranges from reddish-brown to pink. Despite the name, this is often not a mold at all. This growth is often Serratia marcescens, which is actually a bacterium that thrives in damp places like showers, toilets, and bathtubs.
This particular type of mold can look slightly different depending on where it’s growing and the species involved. Typical features include:
Like all molds, this type thrives in moisture. It grows most commonly in areas with:
If there’s excess moisture, there’s a chance mold—including red mold—will develop.
Any type of mold growth indoors can affect indoor air quality. Molds and bacteria release tiny particles into the air, including spores, fragments, and sometimes toxins. Thanks to their small size, these particles can be inhaled, triggering an immune response and potential health issues.
Reactions vary from person to person. Some individuals may have no noticeable symptoms, while others may develop chronic health problems. That’s why all visible mold—including red or pink mold—should be treated as a potential health risk.
The steps for addressing red mold are the same as for any indoor mold problem:
Professional remediation is best for widespread contamination, water damage, or if anyone in the home is experiencing health symptoms.
Yes. Direct contact can cause skin irritation or health reactions. Because mold particles are microscopic, even disturbing a small patch can release spores into the air. It’s best to avoid touching mold and let trained professionals handle removal.
Yes. Some molds that appear red, such as Neurospora, can grow on bread, fruits, and other foods. Moldy food should never be eaten, as it can contain contaminants that may cause digestive problems or more serious health issues.
Red mold can begin growing within 24–48 hours of a moisture problem. Once established, it will start lowering the indoor air quality and degrading the materials it's growing on.
It is commonly found in:
No. "Black mold" usually refers to Stachybotrys chartarum, a species that grows in very wet conditions. Red mold is a color variation of other mold species. Both should be treated as potential health hazards.
Small areas (less than 10 square feet) may be cleaned with proper precautions, but DIY methods make sure to address the roots, particles, and potential toxins. Also, ensure that the issue that led to the growth is addressed. For larger growth or recurring mold, professional remediation is the safest option.
Red mold isn’t a unique species. It’s simply a term for mold that appears reddish during growth. Whether it’s red, black, green, or white, mold indoors is a sign of a moisture problem and should be addressed quickly. Proper remediation restores indoor air quality and helps protect your health.
A member of our team is here to help! Click on “Get Started ➤” below to book a consultation with a member of the HOMECLEANSE team. We have a few quick questions that will help us put together a roadmap to solve or prevent all of your mold problems.
Two minutes of your time could lead to better health for you and your family.
Showing all 4 results

All the equipment and materials we use to remediate your home, plus consultation and support...
-
Shop Now
Remove harmful pollutants that accumulate in the dust of your home. (Options available for renters...
-
Price range: $99.00 through $349.00 Shop Now
Take your cleaning to the next level buying all the tools we use to keep...
-
Price range: $299.00 through $549.00 Shop Now
Turn your HVAC into the healthiest feature of your home.
-
$2,495.00 Shop Now